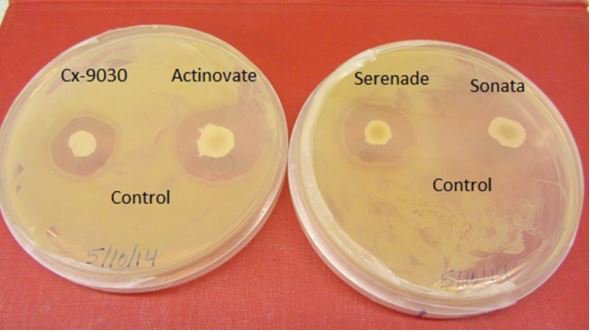
planthealthprog's tweet image. Effectiveness of Chemical Compounds and Biocontrol Agents for Management of Bacterial Spot of Pumpkin... #openaccess bit.ly/2ueZK7l

你可能會喜歡
Plz RT: I’ll be recruiting 2-3 grad students in 2025. If you’re interested in wheat breeding, genetics/genomics of agronomic, quality, pest resistance traits, genomic selection, email me with subject line-CBL studentship. Generous stipend+tuition. We’re based in @CityofEdmonton

Great talk by Syama Chatterton @syamachat from AAFC on the pulse root rot situation in Canada. @tom_warken40864 @agbiousask @CDC_USask
New free ILS webinar: Addressing root rot in pea and lentil, with Syama Chatterton @syamachat youtu.be/M2HWna0gHlM #pea #lentil #rootrot #disease #crea #legumes #ils

Imports of pulses are still active in govt agenda undermining the climate advantage, opportunities and strength of Indian farmers. India could be leading exporter of pulses and oilseeds and edible oil just by supporting smallholder farmers in drylands. @ChouhanShivraj @PMOIndia


Sabine Banniza’s accomplishments as a researcher are making waves as she envisions a country whose pea and lentil crops are resistant to root rot. Read our story and listen to the podcast with this brilliant @agbiousask mind. hubs.li/Q02GXFKy0

Legume Perspectives is a quarterly publication by The International Legume Society (ILS) The latest issue has a special focus on root threats in pulse crops. legumesociety.org/2019/12/02/leg… @TomWarkentin @CDC_USask @agbiousask

Dr. Sabine Banniza has been selected as one of seven 2024 Most Influential Women in Canadian Agriculture! Listen to her live IWCA interview. agwomen.ca/iwca-series-sa…

Hot off the press! New research spearheaded by @MurdochUni and in collaboration with @ICRISAT, @UWAresearch and @BGI_Genomics has revealed the potential of using genetic material from wild crops to bolster cultivated ones. Read the full paper in the latest issue of…

Congratulations to Dr. Sabine Banniza, professor and researcher @CDC_USask @usaskplsc @agbiousask, on being named one of the '2024 Influential Women in Canadian Agriculture' agwomen.ca/?p=122172

Vote for me :) #Aphanomyces #plantpathology
Research the wold needs 1 min video contest at U of S). I tried making a video on what I am working on here at . Below is the link to my video, vote if you like it and make sure to check out cool images and videos from other lab group wshe.es/LPFDxBhw
Research the wold needs 1 min video contest at U of S). I tried making a video on what I am working on here at . Below is the link to my video, vote if you like it and make sure to check out cool images and videos from other lab group wshe.es/LPFDxBhw
CRISPR/Cas9: A Novel Weapon in the Arsenal to Combat Plant Diseases: Ayan Das, Namisha Sharma, Manoj Prasad goo.gl/bRQeVs
Little late on posting, but celebrated valentines day with this amazing pathogen (Aphanomyces euitiches) in Canadian prairies and of course with these amazing people too :) #UofSresearch #pulsepathology #Aphanomyceseuitiches #plantpathology #lovefungi


Coffee faces a double threat to its existence in eastern Ethiopia reut.rs/2IrsEZe
Effectiveness of Chemical Compounds and Biocontrol Agents for Management of Bacterial Spot of Pumpkin... #openaccess bit.ly/2ueZK7l
Yield Losses Due to Crown Rust in Winter Oats in Alabama #openaccess @Crop_Protection bit.ly/2t8Pi1x

Assessment of the Effect of Seed Infection with Ascochyta pisi on Pea in Western Canada: Nimllash T. Sivachandra… goo.gl/VTWRCR
Morel mushrooms really do follow a fire futurity.org/wildfires-more… via @FuturityNews
United States 趨勢
- 1. Black Friday 306K posts
- 2. #releafcannabis N/A
- 3. Good Friday 48.1K posts
- 4. #DaesangForJin 54.6K posts
- 5. #2025MAMAVOTE 99.1K posts
- 6. ARMY Protect The 8thDaesang 58K posts
- 7. #FridayFeeling 1,696 posts
- 8. #ENHYPEN 172K posts
- 9. yeonjun 63.5K posts
- 10. Third World Countries 39.9K posts
- 11. Ravens 60.9K posts
- 12. Mnet 204K posts
- 13. Lamar 48.7K posts
- 14. Sarah Beckstrom 257K posts
- 15. Ilya 21.8K posts
- 16. Mr. President 21.3K posts
- 17. BNB Chain 6,914 posts
- 18. Shane 27K posts
- 19. Jack Ruby N/A
- 20. Cyber Monday 5,125 posts
Something went wrong.
Something went wrong.

































































































